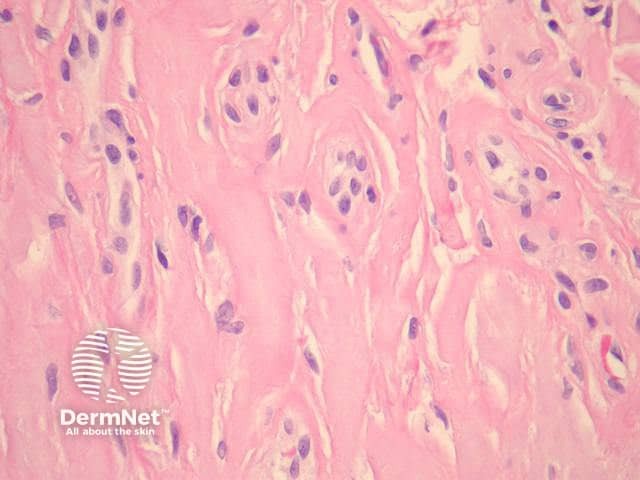
Figure 3

Main menu
Common skin conditions
NEWS
Join DermNet PRO
Read more
Quick links
Author: Dr Harriet Cheng, Dermatology Registrar, Waikato Hospital, Hamilton, New Zealand, 2013.
Erythropoietic protoporphyria (EPP) is a metabolic condition caused by deficiency of the ferrochelatase enzyme leading to intracellular accumulation of haeme precursors. Presentation is with acute photosensitivity in childhood giving rise to erythema and scale and eventually scarring and wax-like thickening of the skin.
In the dermis eosinophilic hyaline material is deposited in and around blood vessel walls. The deposition can be extensive and involve the surrounding dermis to mimic a colloid milium (figures 1,2). Impressive thickening of vessels is seen at higher power examination (figure 3).
Subepidermal blisters similar to those seen in porphyria cutanea tarda are seen in early lesions of EPP. These blisters are cell-poor and inflammatory infiltrate is sparse. ‘Caterpillar bodies’ (linear segmented structures composed of degenerating keratinocytes and basement membrane components) may be seen in the basal layer epidermis overlying blisters.

Figure 1

Figure 2
Figure 3

Figure 4
The hyaline material surrounding blood vessels is PAS-positive (figure 4) and diastase-resistant. Direct immunofluorescence shows deposition of immunoglobulin (especially IgG), fibrin, and C3 around blood vessels in the papillary dermis. Deposition of the membrane attack complex (C5-9) has also been demonstrated in vessel walls.The material also stains positively with Sudan black and Hale’s colloidal iron method. Caterpillar bodies are PAS-positive.
Porphyria cutanea tarda: Histological appearances are very similar. Typically vascular depositis in porphyria cutanea tarda are less pronounced than EPP and limited to the vessel wall. Solar elastosis (often present in PCT due to patient age) is not a feature of EPP.
Scleroderma: The dermal changes of chronic EPP may resemble scleroderma; however, the collagen in EPP is thought to have a looser texture. Blistering and vascular cuffing are not features of scleroderma.
Lipoid proteinosis: Vascular cuffing is a feature of both conditions; however, in EPP, cuffing does not extend around adnexal structures. Clinical correlation can be helpful.
Colloid milium: EPP closely resembles colloid milium when the deposition in the papillary dermis is extensive (figures 1, 2). In colloid milium, clefts form within the material and vascular thickening is not prominent.
Differentiation from other conditions with cell-poor subepidermal blistering (epidermolysis bullosa, pseudoporphyria and bullous amyloidosis) is on the basis of clinical features, immunofluorescence studies and serum, faecal and urine porphyrin testing.